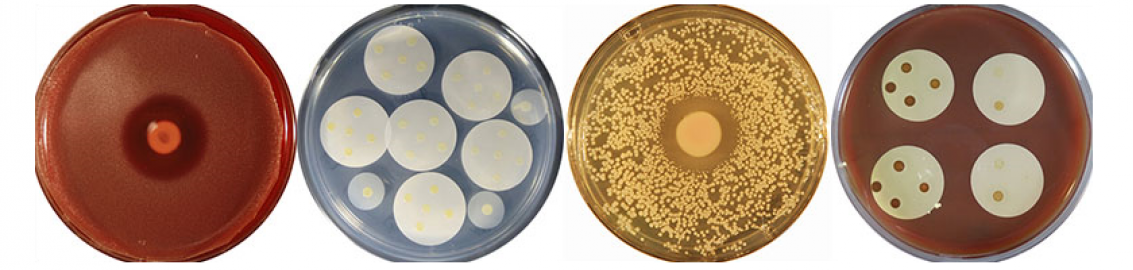
An image of cocultivation assays with human nasal bacterial isolates.

About the Lab
The overarching goal of research in the Katherine Lemon Lab is to identify bacterial strains and bacterial-produced compounds from human nasal microbiota that will lead to new ways to prevent infections. Microbial communities are characterized by a network of interactions with other microbes and their environment. We have identified and developed human nasal microbiota as a model system to address fundamental questions about how host-associated bacteria shape their communities through interspecies interactions.
Five advantages allow us to represent human nasal microbiota in vitro with consortia of small numbers of cultivated species.
- In most adults, two to 10 species make up 90% of a person’s nasal microbiota.
- At a population level, there are 19 common species of nasal bacteria.
- Of these, 18 are cultivated.
- Most common nasal bacteria are genetically tractable.
- Sampling human nasal passages is simple and safe.
We leverage these advantages to develop in vitro assays to identify molecular mechanisms that drive microbial community compositions observed in vivo in the human nasal passages. Through a new collaboration with the Baylor 3D Tissue Cultivation Core, we are incorporating biomimetic organoid models (e.g., human nasanoids) into our microbial cocultivation assays, and expanding our focus from microbe-microbe interactions to also include microbe-epithelium interactions.
Identifying microbiota-based leads for new ways to prevent infections by Staphylococcus aureus and Streptococcus pneumoniae is an ongoing focus in the lab. Both of these pathobionts are common members of human nasal microbiota. And, together, in just the United States, these cause over 30,000 deaths per year and account for 39 percent of cases and 29 percent of deaths attributed to antibiotic-resistant bacteria. Nasal colonization is the primary source of invasive infection by each and is also a key reservoir for transmission. In the absence of an effective vaccine for S. aureus or for nonvaccine serotypes of S. pneumoniae, there is an urgent need for new ways to prevent infections. Blocking nasal colonization by these pathobionts reduces infection and transmission.
Multiple studies of the composition of human nasal microbiota identify specific benign nasal bacterial species that are present when S. aureus is absent in adults and when S. pneumoniae is absent in children. We are identifying molecular mechanisms that underpin these associations and advancing the field from correlation to causation. Application of small molecules or strains of beneficial bacteria to the human nasal passages to block colonization by S. aureus or S. pneumoniae could prevent S. aureus and S. pneumoniae infections, and slow transmission.
Emerging evidence points to nasal microbiota as influencing epithelial response and susceptibility to certain viral respiratory tract infections. We are beginning to explore mechanisms that might underpin these correlations through new collaborative efforts.
Driven by curiosity, our research is multi-disciplinary and we enjoy collaborations with experts in multiple areas of microbial science. These include natural products chemistry, genetic engineering, mass spectrometry, microbial ecology, computational biology, virology, immunology, clinical research and more.
We welcome into the lab a diverse group of curious and compassionate scientists and clinicians at multiple different stages of career development. We are committed to actively improving scientific rigor, transparency and reproducibility. Alumni of the Katherine Lemon Lab are using skills learned in lab in their own research (in academia and biotech), clinical care and consulting. We strive to exemplify the Baylor College of Medicine values of Respect, Integrity, Innovation, Teamwork and Excellence and to be inclusive with regard to race, color, national origin, gender, gender identity and expression, sexual orientation, religion, economic background, veteran status and disability. As a lab, we are actively working to build an anti-racist environment.
We welcome feedback and suggestions as we do this work. Curious about our research? Please see our publications and information on how to join the lab.